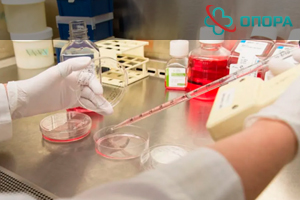
Тест на мефедрон: Полное руководство

Зависимость от него развивается стремительно, а последствия для психики и физического здоровья могут быть необратимыми. Именно поэтому своевременная диагностика употребления этого вещества играет ключевую роль.
Цены на лечение
| Капельница от наркотиков | Стоимость услуги* | |
|---|---|---|
| На дому | 3 500 ₽ | заказать |
| В стационаре | 2 500 ₽ | заказать |
| Кодирование от наркотиков | Стоимость услуги* | |
|---|---|---|
| Подшивание Налтрексон | 33 000 ₽ | заказать |
| Консультация специалистов | Стоимость услуги* | |
|---|---|---|
| Прием врача нарколога | 2 000 ₽ | заказать |
| Реабилитация зависимых | Стоимость услуги* | |
|---|---|---|
| Стандарт (Реабилитация алкозависимых / реабилитация наркоманов) | 40 000 ₽/месяц | заказать |
| Премиум (Реабилитация алкозависимых / реабилитация наркоманов) | 80 000 ₽/месяц | заказать |
| Снятие ломки | Стоимость услуги* | |
|---|---|---|
| Снятие ломки на дому | 6 500 ₽ | заказать |
| В стационаре (амбулаторно) | 7 500 ₽ | заказать |
| В стационаре (сутки) | 8 500 ₽ | заказать |
| УБОД | от 30 000 ₽ | заказать |
Тест на мефедрон: Полное руководство по видам, срокам и методам выявления
Необходимость пройти тест на употребление мефедрона может возникнуть в самых разных ситуациях: от беспокойства близких до требований при трудоустройстве или в рамках судебного разбирательства.
Многие зависимые панически боятся этого момента. То, что они так тщательно скрывали, может внезапно стать достоянием гласности, разрушив отношения, карьеру и репутацию.
Однако тест на мефедрон — это не карательный инструмент, а в первую очередь диагностический метод, который может стать первым шагом на пути к спасению.
В этой статье мы подробно разберем, какие бывают тесты, как они работают, сколько времени наркотик держится в организме и как зависимые могут попытаться обмануть тестирование, нанося вред самим себе.
Что такое мефедрон и в чем его главная опасность?
Чтобы понять, почему тест на выявление мефедрона так важен, нужно осознавать, с каким веществом мы имеем дело. Мефедрон, известный на сленге как «меф», «мяу-мяу» или «соль», является синтетическим психостимулятором, который по своему действию имитирует эффекты амфетамина и кокаина, но зачастую превосходит их по силе и разрушительному потенциалу.
Его главная ловушка — иллюзия контроля и мощная эйфория, которую он дарит на короткое время. Под воздействием мефедрона человек испытывает:
- Прилив энергии и бодрости: Пропадает потребность в сне и еде.
- Обострение чувств: у наркомана создается иллюзия, что музыка звучит интереснее, цвета становятся ярче, общение — искреннее.
- Эмпатию и разговорчивость: Снимаются все социальные барьеры, человек становится предельно откровенным и уверенным в себе (несмотря на то, что со стороны для трезвого человека такая самоуверенность будет видеться неадекватной и необоснованной)
- Повышенное либидо: Возрастает сексуальное влечение, часто доходя до рискованного поведения чуть ли не животного уровня.
Эта яркая вспышка эйфорических эмоций очень быстро сменяется тёмной реальностью. Негативное воздействие на центральную нервную систему колоссально. При регулярном употреблении наркотика проявляются тяжелейшие побочные эффекты:
- Психические расстройства: Паранойя, галлюцинации, панические атаки, тяжелая депрессия и суицидальные мысли становятся постоянными спутниками.
- Физическое истощение: Организм, работающий на износ без сна и питания, быстро теряет ресурсы. Это приводит к резкой потере веса, проблемам с кожей, волосами и зубами.
- Сердечно-сосудистые проблемы: Нарушения сердечного ритма, резкие скачки артериального давления, спазмы сосудов могут привести к инфаркту или инсульту даже у молодых людей.
- Неврологические нарушения: Характерные признаки включают непроизвольные судороги лицевых мышц, скрежет зубами (бруксизм) и провалы в памяти.
Зависимость формируется практически молниеносно, порой уже после нескольких употреблений, а «ломка» сопровождается невыносимым психологическим дискомфортом, что толкает человека на поиски новой дозы любой ценой.
Когда и зачем нужно сдать тест на мефедрон?
Решение провести тестирование редко бывает спонтанным. Обычно за ним стоят серьезные причины и веские подозрения. Давайте рассмотрим основные ситуации, когда это становится необходимостью.
Подозрения со стороны семьи. Близкие люди первыми замечают тревожные изменения в поведении: резкие перепады настроения, скрытность, появление странных друзей, финансовые проблемы, необъяснимые исчезновения из дома. В этом случае тест на мефедрон становится способом прояснить ситуацию и либо развеять страхи, либо подтвердить их и начать действовать.
Трудоустройство и профессиональные осмотры. Для ряда профессий, связанных с высокой ответственностью, безопасностью и концентрацией внимания, проверка на наркотики является обязательной. К ним относятся:
- Сотрудники правоохранительных органов и силовых структур.
- Военнослужащие.
- Пилоты, водители общественного и грузового транспорта.
- Врачи и медицинский персонал.
- Работники на опасных производствах.
Правовые и судебные разбирательства. Тестирование является неотъемлемой частью расследования при дорожно-транспортных происшествиях, нападениях, убийствах и других преступлениях, где есть основания полагать, что виновник находился в состоянии наркотического опьянения.
Массовые проверки в учебных заведениях. В школах, колледжах и университетах могут проводиться плановые или внеплановые тестирования для профилактики и раннего выявления наркомании среди молодежи.
Виды тестов: от домашней полоски до высокоточной лаборатории
Все существующие методы диагностики можно условно разделить на две большие группы: качественные и количественные. Понимание их различий — ключ к выбору правильного подхода.
Качественные методы: быстрый ответ «Да» или «Нет»
Эти тесты не показывают концентрацию вещества, а лишь фиксируют сам факт его наличия (или его метаболитов) в организме. Их главные преимущества — скорость, простота и доступность.
- Простота использования: Не требуют сложного оборудования или специальных навыков.
- Экономичность: Стоимость таких тестов минимальна.
- Быстрый результат: Ответ можно получить в течение 5-15 минут.
- Достаточная надежность: Для предварительной диагностики в формальных случаях их точности вполне хватает.
К этой группе относится популярный экспресс тест на мефедрон. Чаще всего он представляет собой иммунохроматографический анализ (ИХА). Проще говоря, это тест-полоска или кассета, на которую нанесены специальные антигены.
Когда биологический материал (чаще всего моча) проходит через фильтр, антитела к мефедрону (если они есть) вступают в реакцию с этими антигенами. Появление одной контрольной полоски и отсутствие тестовой говорит о положительном результате.
Важно понимать: результаты качественных тестов считаются предварительными и не имеют юридической силы. Они — идеальный инструмент для домашнего использования или первичного скрининга, но для официального заключения потребуется лабораторное подтверждение.
Количественные методы: точность, имеющая юридическую силу
Эти исследования проводятся исключительно в специализированных лабораториях с использованием высокотехнологичного оборудования. Они позволяют не только подтвердить факт употребления, но и определить точную концентрацию наркотика в биоматериале. Это, в свою очередь, может дать представление о дозировке и давности приема.
Результаты таких анализов являются окончательными и могут использоваться в суде. Основные методы, которые применяются для выявления мефедрона:
- Газовая хромато-масс-спектрометрия (ГХ-МС): Считается «золотым стандартом» в наркологической диагностике. Метод разделяет пробу на отдельные компоненты и с высочайшей точностью идентифицирует каждый из них.
- Жидкостная хромато-масс-спектрометрия (ВЭЖХ-МС): Схожий по принципу метод, также обладающий высочайшей чувствительностью и специфичностью.
Эти методы позволяют обнаружить даже следовые, ничтожные концентрации вещества, исключая вероятность ошибки. Если стоит вопрос, какой тест на наркотики покажет мефедрон со 100% гарантией, то ответ однозначен — это лабораторная хромато-масс-спектрометрия.
Какой биоматериал использовать? Сроки обнаружения мефедрона
Срок, в течение которого можно обнаружить наркотик, напрямую зависит от типа биоматериала, частоты употребления, дозировки и индивидуальных особенностей метаболизма человека.
Тест на мефедрон в моче: самый распространенный метод
Моча — наиболее часто используемый биоматериал для скрининга. Это связано с тем, что метаболиты наркотика выводятся из организма преимущественно через почки и накапливаются в урине в высокой концентрации.
Сроки обнаружения:
- При разовом употреблении мефедрон можно обнаружить в течение 2-3 дней.
- При систематическом употреблении (несколько раз в неделю) этот срок увеличивается до 5-7 дней и даже больше.
Для анализа мочи чаще всего сначала используется аптечный тест на мефедрон. Если он показывает положительный результат, образец отправляют в лабораторию для подтверждающего количественного анализа.
Анализ мочи является относительно недорогим и информативным способом, который позволяет получить достоверный результат. Интересной особенностью является то, что образцы мочи можно анализировать даже спустя полтора месяца, если они правильно хранились в холодильнике.
Анализ крови: точный, но краткосрочный
Кровь показывает картину «здесь и сейчас». Она информативна для определения недавнего употребления или острого опьянения.
Сроки обнаружения: Мефедрон и его активные метаболиты циркулируют в крови относительно недолго — от 12 до 48 часов после последнего приема.
Существует два основных вида анализа крови:
- Химико-токсикологический анализ (ХТИ): Проводится с помощью хромато-масс-спектрометрии и выявляет непосредственно само вещество. Используется для подтверждения факта недавнего употребления.
- Иммунологическое исследование (квартальный тест): Этот метод ищет не сам наркотик, а антитела к нему, которые вырабатываются организмом в ответ на употребление. Такие антитела могут сохраняться в крови до 3-4 месяцев, что позволяет доказать факт употребления в прошлом, даже если самого вещества в организме уже нет. Однако этот тест не сможет выявить разовый прием.
Анализ волос: долгосрочный архив употребления
Волосы — уникальный биоматериал. По мере роста они, как лента самописца, фиксируют все химические вещества, которые попадали в кровоток.
Сроки обнаружения: Метаболиты мефедрона откладываются в структуре волоса и могут быть обнаружены в течение 3-4 месяцев и более после последнего употребления.
Исследуя разные участки волоса (ближе к корню — недавнее употребление, на кончиках — давнее), специалисты могут составить целую хронологию приема наркотика. Этот метод невероятно точен, но из-за своей высокой стоимости и сложности в России применяется реже, чем в странах Европы и США, в основном в сложных судебно-медицинских экспертизах. Анализ волос информативен даже после смерти человека, что открывает широкие возможности для криминалистов.
Анализ слюны: быстрый, но ограниченный
Слюна используется для тестирования реже всего.
Сроки обнаружения: Мефедрон обнаруживается в слюне в очень небольших количествах и в течение крайне короткого времени — всего несколько часов после приема.
Из-за своей малой информативности для выявления мефедрона этот метод практически не применяется.
Экспресс-тесты: что нужно знать перед покупкой в аптеке
Когда возникает острая необходимость проверить близкого человека, первым решением часто становится поход в аптеку. Аптечный тест на мефедрон — это удобно, анонимно и быстро. Самые распространенные на рынке:
- DMEP-101 (Китай)
- «Будьте уверены» (Россия)
- Мультитесты «Нарко-Экспресс» (позволяют одновременно проверить наличие 5, 10 или 12 видов наркотиков, включая катиноны).
Принцип их действия прост. Полоска опускается в емкость с мочой до определенной отметки на 10-15 секунд, после чего кладется на сухую поверхность. Результат оценивается через 5-10 минут.
Но есть важные нюансы:
- Чувствительность: Большинство тестов срабатывают при концентрации мефедрона в моче от 100 нг/мл. Если доза была небольшой или прошло уже достаточно много времени, тест может дать ложноотрицательный результат.
- Предварительный характер: Помните, что данные, полученные с помощью тест-полосок, не являются официальным диагнозом. В случае положительного результата необходимо обратиться в наркологическую клинику для проведения лабораторной диагностики.
- Риск ошибки: Неправильное использование, истекший срок годности или слишком разбавленная моча могут исказить результат.
Как наркоманы пытаются обмануть тест на мефедрон?
В попытке скрыть свою зависимость многие наркоманы ищут способы повлиять на результаты тестирования. В интернете можно найти массу «советов», большинство из которых абсолютно бесполезны и даже опасны.
Популярные мифы и их разоблачение:
- Домашняя детоксикация. Усиленное питье воды, прием мочегонных, интенсивные тренировки, баня. Эти методы действительно могут незначительно ускорить выведение метаболитов из организма, но они сработают только при единичном употреблении небольшой дозы. При систематическом приеме наркотик накапливается в жировой ткани, и «вымыть» его за пару дней невозможно. Лабораторный анализ все равно его покажет.
- Подмена или разбавление биоматериала. Попытка сдать чужую мочу или разбавить свою водой — самый распространенный способ обмана. Однако в условиях клиники этот трюк не пройдет. Забор биоматериала происходит под контролем медперсонала. Лаборанты также проверяют температуру, плотность и pH образца. Любое отклонение от нормы сразу вызовет подозрения, и анализ будет назначен повторно.
- Прием специальных препаратов. На рынке существуют так называемые «антидоты» и «очищающие средства». Их эффективность не доказана, а состав зачастую неизвестен и может быть опасен для здоровья.
Обмануть тест на мефедрон в моче, проводимый в домашних условиях, теоретически возможно. Но сфальсифицировать результаты лабораторного исследования крови или волос — практически нереально, так как забор биоматериала полностью контролируется специалистами.
Самое главное — нужно понимать бессмысленность и критическую опасность этих уловок для самих себя. Даже если удастся обмануть тест один раз, это не решит главную проблему — зависимость. Болезнь продолжит прогрессировать, разрушая человека изнутри, и рано или поздно правда все равно вскроется, но последствия могут быть уже куда более трагичными.